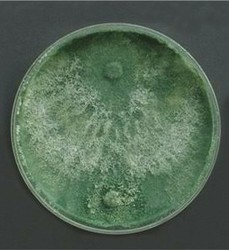
تجزیه زیستی انواع پلیمرها توسط میکرو ارگانیسم قارچی

سجاد عظیمی1، عباس عظیمی2، میثم گرامی پور3
1کارشناسی ارشد بیوتکنولوژی دانشگاه اصفهان، 2رئیس تایرسازی شرکت کویرتایر ،3رئیس استیل لاستیک شرکت کویر تایر
چکيده:
آلودگی حاصل از پلیمرها مساله ای مهم است که باید به آن توجه شود چرا که خطراتی برای محیط زیست و جانداران در بر خواهد داشت، تاکنون روش هایی برای دفع و استفاده مجدد پلیمرها مطرح شده است، طبیعیست که روش هایی مانند پیرولیز و آتش زدن ضایعات خطرات و آلودگی برای محیط دارند، همچنین اگر ضایعات در محیط رها شوند، آتش سوزی در پی دارد، از طرفی ضایعات لاستیکی محلی خوب برای حشرات از جمله مالاریا است، این ها خود دلایلی برای دفع بهتر این ضایعات است، بهترین روش، روش تجزیه زیستی امی باشد که تحقیقات در این حوزه ادامه دارد، در این مقاله سعی شده بخشی از کار تحقیقاتی در این حوزه بیان شود که نتیجه دریافتی با کارهای قبلی که با این سویه قارچی انجام شده بود، مطابقت داشته البته می توان برای بهبود تجزیه از روش های پیش فرآوری استفاده کرد.
واژگان کلیدی: پلیمر،تجزیه،لاستیک، میکروارگانیسم
مقدمه
آلودگی حاصل از پلیمرها در جهان به مسالهای مهم تبدیل شده است، بطور نمونه درمورد تجزیه زیستی پلی اتیلن، پلیپروپیلن، پلیالفین (محصولاتی بر پایه پلیاتیلن و پلیپروپیلن)، لاستیک طبیعی و غیره کار شده که در ادامه برای هرکدام اطلاعاتی آمدهاست.
تئوری
پلی الیفین ها به دلیل خاصیت فیزیکی، شیمیایی و ماهیت خود کاربردهای گسترده ای پیدا کرده اند، بطوریکه در سال 2004 حدود 20 تا 30 درصد از کل فروش پلیمر در ایالات متحده و کانادا را به خود اختصاص دادند (1) بنابراین حدود 50 درصد از زبالههای پلاستیکی موجود در محیط به این دسته اختصاص دارد (2) تخریب پلیالیفین در طبیعت بسیار کند است که منجر به تجمع آنها در محیط به مقدار 25 میلیون تن در سال میشود (3) تشکیل بیوفیلم یا اتصال میکروارگانیسمها برروی پروپیلن به دلیل ماهیت آبگریز بسیار ضعیف است (4) دیگر پلیمر مورد اشاره لاستیک طبیعی که از درخت هیوآ بریزیلینسیس مشتق میشود که خاصیتی چسبنده و حساس به دما میباشد، بنابراین بطور خالص نمیتوان برای ساخت محصولات لاستیکی استفاده کرد، مگر اینکه ولکانیزه شود (5) با توجه به خصوصیات لاستیک، استفادههای متنوعی از آن میشود، طبق آمار سال 2013، میزان مصرف جهانی لاستیک 12.5 میلیون تن بودهاست که 65 درصد آن برای تولید تایر و 35 درصد آن برای ساخت دیگر محصولات مورد استفاده قرار گرفته است(6).
همچنین مصرف جهانی پروپیلن در سال 2010 میزان 50 میلیون تن با رشد متوسط سالانه حدود 8 درصد تخمین زده شده است، بطور مثال مصرف پلاستیک در هند 5 کیلوگرم می باشد(7).
بعد استفاده از محصولات پلیمری به کار برده شده در صنعت، دفع آنها معضل بزرگی است که در سراسر جهان گرفتار آن هستند، اولویتهای پیشنهادی برای کاهش حجم ضایعات این نوع مواد به این ترتیب میباشد که کاهش مصرف، استفاده مجدد از محصول، بازیافت مواد و بازیابی انرژی است، به علت شبکه اتصالات متقاطع شیمیایی، صرفاً ذوب و تغییر شکل لاستیک امکانپذیر نیست، برای استفاده مجدد از مواد پلاستیکی، فرآیندهای ویژهای مانند پیرولیز و سایر روشهای گرمایی باید انجام شود، در طول فرآوری با این روشها، ممکن است ماده تا حدی تخریب شود و ویژگی اصلی خورد را به دست نیاورد، در صورت سوختن مقدار زیادی دی اکسیدکربن، گاز کلر ایجاد می شود که مشکلات محیطی را ایجاد کرده و به گرم شدن کره زمین کمک میکند، محصولات لاستیک طبیعی مانند تایر حاوی 1.5 درصد وزنی مواد خطرناک هستند، اگر در محل دفن زباله ریخته شود، حوادث آتش سوزی رایجی دارند(5).
سوزاندن تایرها در هوای آزاد ذرات و گازهایی مانند ترکیبات گوگرد، هیدروکربن ها و اکسیدهای کربن و ازت را آزاد می کند که برای انسان و محیط زیست سمیست، این فرآیند همچنین روغن پیرولتی سمی را به محیط آزاد می کند، تخمین زده می شود که یک تایر اتومبیل، تنها در هنگام سوختن حدود 7.5 لیتر روغن پیرولیتی آزاد می کند، خاموش کردن آتش با آب نیز میتواند باعث آلودگی خاک وآب شود، حتی ذخیره لاستیک می تواند باعث بوجود آمدن محل زندگی برای پشه ها از جمله مالاریا شود(5).
همچنین اگر محصولات لاستیکی مانند بادکنک، کیسه، لوله و دستکش وغیره در محیط رها شوند می تواند خطرهایی برای سایر حیوانات داشته باشد، اگر محصولات لاستیکی توسط حیوانات خورده شود، چون یک پلیمر بوده و قابل هضم نیست باعث مرگ حیوانات می شود (5).
یکی از گزینه های مدیریت زباله محصولات لاستیکی، سوزاندن می باشد، با این حال، یک فرآیند ساده نیست، دستگاه زباله سوز باید به درستی برای کنترل انتشار گازها طراحی شده باشد و برای پاک سازی آلودگی هایی مانند کلر به دستگاه اسکرابر مجهز باشد، انتشار کلر به طور کلی از سوزاندن زباله محصولات لاستیکی و ضایعات حاوی پلیمرهای کلروپن ناشی می شود، اسکرابرها محصول اسیدی تولید می کنند که ممکن است قبل از تخلیه خنثی شود، تقریباً همه ترکیبات لاستیکی حاوی نوعی از پرکننده ها ، یا کربن سیاه ، خاک رس ، کربنات کلسیم یا ترکیبات سیلیس آبرسان هستن، هنگامی که این ترکیبات لاستیکی سوزانده می شوند ، دود خاکستری تولید می کنند که ممکن است حاوی فلزات سنگین مانند روی باشد، بنابراین روش سوزاندن راه حل مناسبی برای از بین بردن زباله های لاستیکی نیست (8).
یکی از راه های غلبه بر مشکلات زیست محیطی، تبدیل میکروبی لاستیک به محصولات مفید است، مزایای خاص زیادی از فرآیندهای بیوتکنولوژیکی در مقایسه با استفاده از روش های شیمیایی و فیزیکی وجود دارد، روش بیوتکنولوژی هیچ ماده شیمیایی مضر یا سمی تولید نمی کند و به طور معمول انرژی زیادی نیاز ندارد، با این حال هنوز موانعی بر سر راه این روش وجود دارد، مهمترین آنها حساسیت میکروارگانیسم ها نسبت به بسیاری از مواد شیمیایی، از جمله مواد افزودنی لاستیکی، که برای بهبود پایداری و عملکرد لاستیک در طیف وسیعی از دما استفاده می شود (5،7) تخریب میکروبی محصولات لاستیکی مورد توجه بسیاری قرار گرفته است و مطالعات بسیاری در مورد تخریب هر دو الاستومرهای لاستیکی خالص و محصولات لاستیکی ولکانیزه شده توسط باکتری ها و اکتینومیست ها انجام شده است (9).
قارچها، ارگانیسم های دارای پتانسیل برای تجزیه بیولوژیکی می باشند، زیرا از منبع غنی آنزیم های تخریبکننده برخوردار بوده و توانایی زنده ماندن در محیطهای سخت و شرایط کمبود مواد مغذی و رطوبت را دارند، آنها توانایی پخش شدن و نفوذ به روزنه ها و شکاف ها از طریق توزیع هیفا را دارند (1). گزارش شده است که قارچ آسپرژیلوس نایجر نیز برای تخریب پلی پروپیلن استفاده شده است (10). در مطالعاتی اثرات هم افزایی UV و حرارتی در تخریب پلی پروپیلن پیش تصفیه شده با کنسرسیوم خاک(11) و اثرات محیطهایی از جمله خاک، اقیانوس و نور مستقیم خورشید در تجزیه بیولوژیکی نشاسته و کاتالیزور مخلوط پلی اتیلن با چگالی بالا و پلی پروپیلن گزارش شده است (12).
جداسازی میکروارگانیسم
مرحله اول، انتخاب و یا جداسازی گونه میکروارگانیسم میباشد، برای جداسازی و انتخاب گونه میکروارگانیسم می توان نمونه خاکی از محل دفن زباله جمع آوری کرد و در نهایت نمونه مورد نظر را انتخاب کرد(5).
جداسازی باکتریهای تخریب کننده لاستیک طبیعی مطابق روش انتخاب نمونه از محل دفن خاک انجام شد، دیسک های لاستیکی کوچک، توزین و وزن اولیه آنها ثبت شد، سپس این دیسک ها در خاک ریخته می شوند و برای مدت زمان شش ماه باقی می مانند، به طور مرتب در فواصل زمانی دو ، چهار و شش ماه برداشته و وزن می شوند، برای جداسازی باکتریهای تجزیه کننده لاستیک طبیعی نمونه خاک و نمونه های لاستیک طبیعی در معرض مواد مغذی قرار داده شده و برای مدت 24 ساعت در دمای اتاق (37 درجه سانتیگراد) نگهداری می شوند(13).
در این پژوهش از یک نمونه قارچ جهت تجزیه پلی اتیلن، لاستیک طبیعی، استایرن بوتادین و نوکلئوپرن استفاده شد.
آماده سازی نمونه پلیمر و کشت در محیط مایع قارچی
برای این کار قطعات یک سانتی متری از پلیمرها تهیه شد، نمونه های پلیمری در محیط کشت قارچی برای مدت زمان 3 ماه بدون پیشفرآوری خاصی کشت داده شدند. محیط کشت حاوی 0.3 گرم NH4NO3، 0.5گرم K2HPO4، 0.1گرمNaCl، 0.02گرمMgSO4.7H2O، 2 گرم آگار بود (14). قبل از کشت مایع، در محیط کشت جامد نمونه ها تست شد که بعد از 72 ساعت تست، هالهای از توده قارچی اطراف پلیمرها را می گیرد، بهترین حالت مربوط است به پلی اتیلن، لاستیک طبیعی، استایرن بوتادین و نوکلئوپرن. قابل ذکر است که بعد از ولکانیزه شدن پلیمرها، گوگرد خاصیت سمی برای میکروارگانیسم ها دارد و رشد آن ها را کند می کند. سپس در محیط مایع، کشت 3 ماهه برای هر نمونه انجام شد، که از هر نمونه 3 کشت همزمان برای کنترل بهتر صورت گرفت.

شکل-1 قارچ تریکودرمای در محیط کشت جامد
بعد از گذشت 1 ماه، هر هفته به مدت 2 بار نمونهگیری از هرکدام به عمل آمد و فعالیت آنزیمی لاکاز و منگنز پروکسیداز گرفته شد.
فعالیت لاکاز
برای فعالیت لاکاز می توان از چند روش استفاده کرد که ما در ادامه به تشریح روش مورد استفاده شده می پردازیم.
تولید لاکاز با ایجاد رنگ قهوه ای به دلیل اکسیداسیون گویاکول که در 450 نانومتر ثبت شده است، شناسایی
می شود، مخلوط واکنش شامل 3 میلی لیتر بافر استات، یک میلی لیتر گویاکول و یک میلی لیتر آنزیم می باشد، همچنین بلانک حاوی 1 میلی لیتر آب بجای آنزیم بوده، نمونه ها در دمای 30 درجه سانتی گراد به مدت 15 دقیقه انکوبه شدند و در جذب 450 نانومتر فرآیند انجام شد، فعالیت آنزیمی با واحد UI یا U سنجیده می شود که در آن هر یک UI به مقدار آنزیم مورد نیاز برای اکسیداسیون یک میکرومول گویاکول در هردقیقه تعریف می شود، فعالیت لاکاز با فرمول زیر محاسبه می شود(15)
EA=(A.V)/(t.e.v)
که:
EA: فعالیت آنزیمی (U/ml)
A: جذب در 450 نانومتر
V: کل حجم مخلوط واکنش (ml)
v: حجم آنزیمی (ml)
t: زمان انکوباسیون (دقیقه)
e: ضریب انقراض
فعالیت منگنز پراکسیداز
با استفاده از روش اکسیداسیون فنول قرمز در 610 نانومتر اندازه گیری شد، مخلوط واکنش با 500 میکرولیتر آنزیم استخراجی، 100 میکرولیتر فنول قرمز (0.01درصد وزنی/ حجمی)، 100 میکرولیتر سدیم لاکتات (0.25 مولار)، 200 میکرولیتر سرم آلبومین گاوی (0.5 درصد وزنی/حجمی)، 50 میکرولیتر MnSO4 (2میلی مولار)، 50 میکرولیتر (آب اکسیژنه) در بافر سوکسینات سدیم 20 میلی مولار با pH 4.5 مخلوط و در 30 درجه سانتی گراد برای 5 دقیقه انکوبه شد و سپس جذب آن در 610 نانومتر انجام گرفت، برای بلانک نیز محیط کشت خالی استفاده شد که فرمول محاسبه فعالیت منگنز پراکسیداز بصورت زیر است: (16)
Abs.106/e.R.t
Abs: میزان جذب
e: ضریب از بین رفتن فنول قرمز اکسیدشده
R: کسری از عصاره آنزیمی (میلی لیتر)
t: زمان واکنش
نتیجه گیری
بهترین نتیجه به دست آمده بعد از 3 ماه انکوبه شدن در این کار در جدول زیر آمده است، گونه قارچی انتخابی توانست به میزان قابل قبولی باعث تجزیه پلیمرها شود، همچنین با پیش فرآوری هایی میتوان سرعت تجزیه را بالا برد.
جدول1: فعالیت آنزیمی در بهترین حالت
|
نمونه |
آنزیم لاکاز |
آنزیم منگنز پراکسیداز |
|
لاستیک طبیعی |
0.015482 |
0.010762 |
|
پلی اتیلن |
0.00989 |
0.013453 |
|
استایرن بوتا دی ان |
0.007135 |
0.008072 |
|
استایرن بوتا دی ان روغنی |
0.006915 |
0.007175 |
|
نوکلئوپرن |
0.010606 |
0.005381 |
تجزیه پلیمرها نیاز به آزمایشات دیگری نیز دارد که از جمله آن ها FTIR،NMR،XRD،SEM و سایر روش ها می باشد، این آنزیم های تولید شده توسط میکروارگانیسم اولین مرحله برای انجام سایر آزمایشات می باشد چرا که این آنزیم ها باعث شکستن زنجیر پلیمری می شوند، طبیعی است اگر پیش فرآوری روی پلیمرها انجام شود نتیجه بهتری بدست خواهد آمد.
منابع
- Artham T, Doble MJB. Biodegradation of physicochemically treated polycarbonate by fungi. 2010; 11(1):20-8.
- Sivan A, Szanto M, Pavlov VJAm, biotechnology. Biofilm development of the polyethylene-degrading bacterium Rhodococcus ruber. 2006: 72(2):346-52.
- Orhan Y, Büyükgüngör HJIb, biodegradation. Enhancement of biodegradability of disposable polyethylene in controlled biological soil. 2000:
45(1-2):49-55. - Singhania RR, Christophe G, Perchet G, Troquet J, Larroche CJBt. Immersed membrane bioreactors: an overview with special emphasis on anaerobic bioprocesses. 2012: 122:171-80.
- Nayanashree G, Thippeswamy BJEP. Biodegradation of natural rubber by laccase and manganese peroxidase enzyme of Bacillus subtilis. 2015:2(4):761-72.
- Tsuchii A, Tokiwa YJJob, bioengineering. Colonization and disintegration of tire rubber by a colonial mutant of Nocardia. 1999: 87(4):542-4.
- Arkatkar A, Juwarkar AA, Bhaduri S, Uppara PV, Doble MJIB, Biodegradation. Growth of Pseudomonas and Bacillus biofilms on pretreated polypropylene surface. 2010: 64(6):530-6.
- Tsuchii A, Tokiwa YJBl. Microbial degradation of tyre rubber particles. 2001: 23(12):963-9.
- Bredberg K, Andersson BE, Landfors E, Holst OJBT. Microbial detoxification of waste rubber material by wood-rotting fungi. 2002: 83(3):221-4.
- Cacciari I, Quatrini P, Zirletta G, Mincione E, Vinciguerra V, Lupattelli P, etal. Isotactic polypropylene biodegradation by a microbial community: physicochemical characterization of metabolites produced. 1993: 59(11):3695-700.
- Arkatkar A, Arutchelvi J, Bhaduri S, Uppara PV, Doble MJIB, Biodegradation. Degradation of unpretreated and thermally pretreated polypropylene by soil consortia. 2009: 63(1):106-11.
- Muthukumar T, Aravinthan A, Lakshmi K, Venkatesan R, Vedaprakash L, Doble MJIB, et al. Fouling and stability of polymers and composites in marine environment. 2011: 65(2):276-84.
- Tsuchii A, Takeda K, Suzuki T, Tokiwa YJB. Colonization and degradation of rubber pieces by Nocardia sp. 1996: 7(1):41-8.
- Sowmya H, Krishnappa M, Thippeswamy BJEm, assessment. Degradation of polyethylene by Trichoderma harzianum—SEM, FTIR, and NMR analyses. 2014: 186(10):6577-86.
- Ranimol G, Venugopal T, Gopalakrishnan S, Sunkar SJB, biotechnology a. Production of laccase from Trichoderma harzianum and its application in dye decolourisation. 2018: 16:400-4.
- Bonugli-Santos RC, Durrant LR, Da Silva M, Sette LDJE, Technology M. Production of laccase, manganese peroxidase and lignin peroxidase by Brazilian marine-derived fungi. 2010: 4-7-32(1)6.
